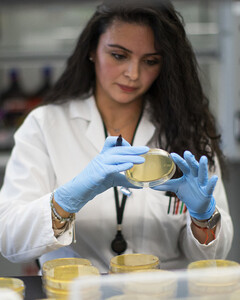
Твиндемия (союз covid-19 и гриппа) — новая угроза человечеству

В недавнем интервью основатель Microsoft и миллиардер Билл Гейтс рассказал, что может помочь людям в непростой период пандемии. Он уверен, что человечество сможет вернуться к нормальной жизни без ограничений и риска заболеть COVID-19 исключительно в том случае, если появится эффективная, безопасная и доступная для всех слоёв населения вакцина. Только массовая вакцинация, по мнению Билла Гейтса, поможет вывести людей на прежний уровень жизни и остановить распространение опасного вируса.
Ещё в апреле один из богатейших людей мира говорил о том, что пандемия, скорее всего, продлится до 2022 года. По его мнению, США сможет вернуться к нормальной жизни на год раньше только в том случае, если разработки вакцины будут удачными, а результат будет общедоступен. Он выразил огорчение в связи с тем, что американские власти наверняка не будут спешить распространять вакцину в другие страны, особенно те, которые имеют низкий уровень экономики.

Одновременно с этим миллиардер призвал отнестись к разработке вакцины от коронавируса максимально серьёзно, поскольку любая гонка и соперничество приведут к тому, что на рынке появятся небезопасные препараты с огромным количеством побочных эффектов. Прежде всего, они должны пройти многочисленные тесты, и лишь потом их можно будет применять для борьбы с COVID-19.
Напомним, что Билл Гейтс и его супруга Мелинда являются основателями благотворительного фонда, который финансирует ВОЗ и выделяет миллионы долларов на борьбу с коронавирусом.
Источник фото: Gettyimages
Читайте самое интересное от Mainstyle на ЯНДЕКС.ДЗЕН

Комментарии